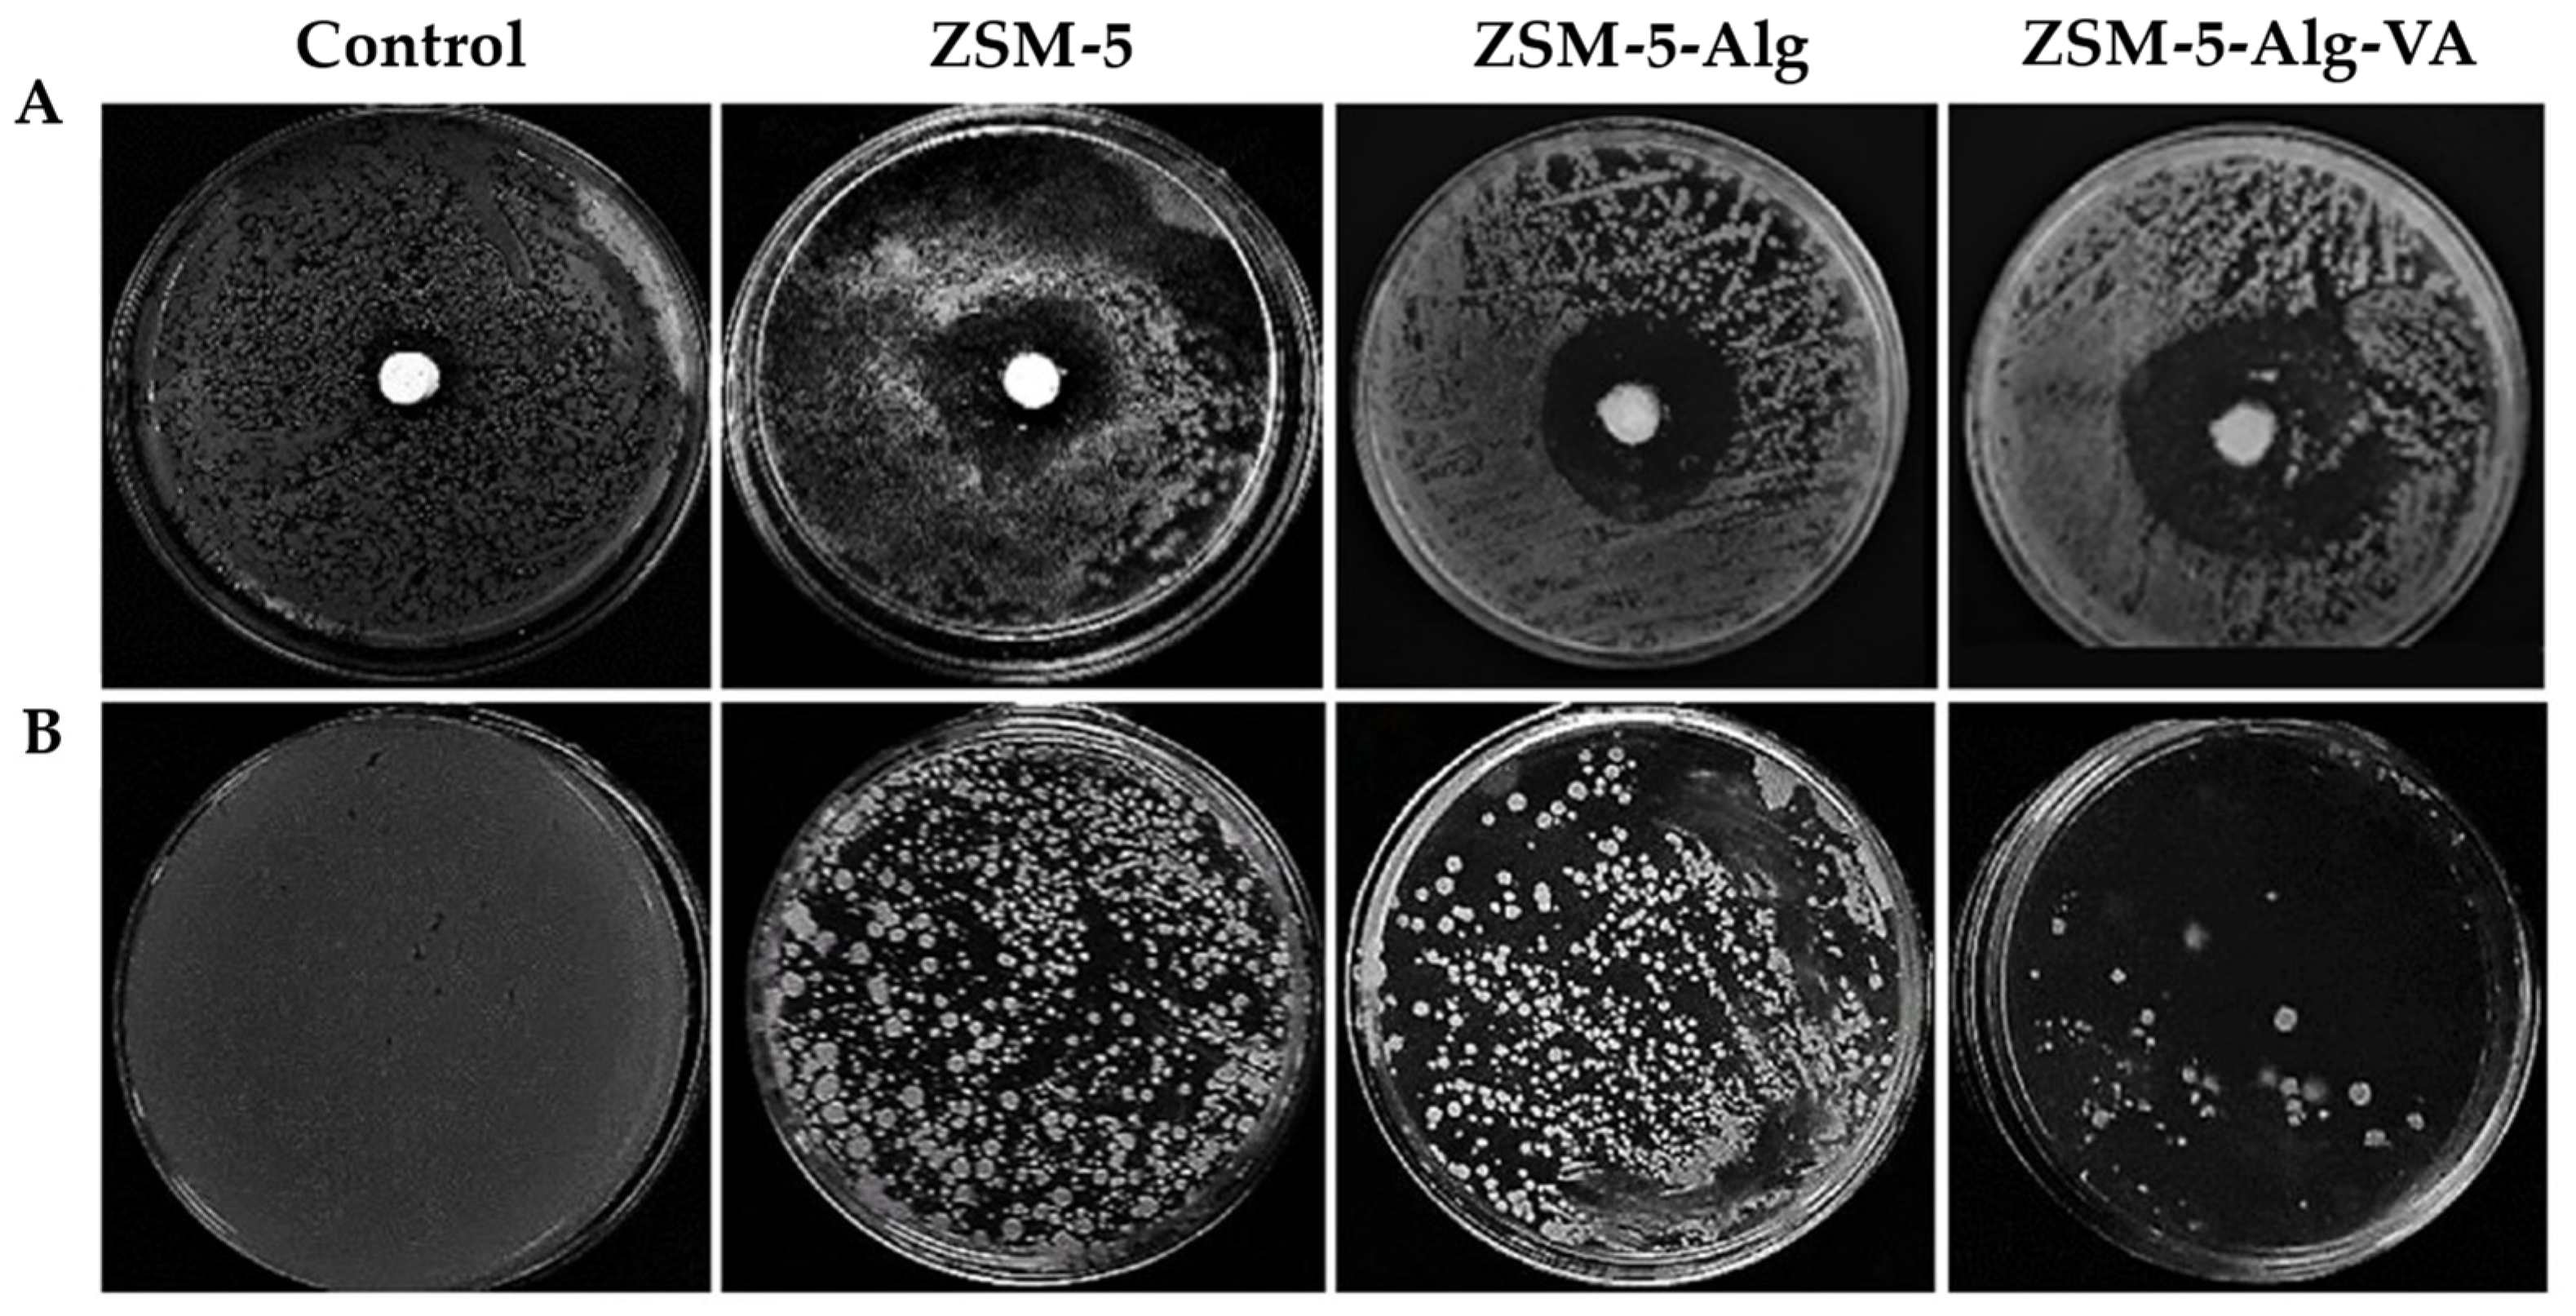

Natural and Synthetic Clay Minerals in the Pharmaceutical and Biomedical Fields
Abstract
1. Introduction
2. Structure of Clay Minerals
3. Current Use of Clay Minerals in the Pharmaceutical and Biomedical Field
4. Natural Clays
4.1. Montmorillonite
4.1.1. Drug Delivery Applications
4.1.2. Tissue Engineering Applications
4.2. Halloysite
4.2.1. Drug Delivery Applications
4.2.2. Tissue Engineering Applications
4.3. Sepiolite and Palygorskite
4.3.1. Drug Delivery Applications of Sepiolite
4.3.2. Tissue Engineering Applications of Sepiolite
4.3.3. Drug Delivery Applications of Palygorskite
4.3.4. Tissue Engineering Applications of Palygorskite
5. Synthetic Clays
5.1. Synthesis Strategies of Clay Minerals
5.2. Laponite
5.2.1. Drug Delivery Applications
5.2.2. Tissue Engineering Applications
5.3. Layered Double Hydroxides

5.3.1. Drug Delivery Applications
5.3.2. Tissue Engineering Applications
5.4. Zeolites
- (A)
- Pore size (depending on the interparticle arrangement of zeolites channels and cavities):
- -
- Microporous, having pore diameter <2 nm;
- -
- Mesoporous, having pore diameter 2–50 nm;
- -
- Macroporous, having pore diameter >50 nm;
- (B)
- Acidity (depending on the Si/Al ratio):
- -
- Low silica (Si/Al ratio 1.0–1.5) (Zeolite X);
- -
- Intermediate silica (Si/Al ratio 2.0–3.0) (Zeolite Y);
- -
- High silica (Si/Al ratio 10–250) (Zeolite ZSM-5).
- -
- Low density and a large volume of free spaces;
- -
- High degree of hydration;
- -
- High degree of crystallinity;
- -
- High internal surface area, causing the adsorption of molecules and ions;
- -
- Ion exchange ability;
- -
- Catalytic ability [138].
5.4.1. Drug Delivery Applications
5.4.2. Tissue Engineering Applications
6. Conclusions
Author Contributions
Funding
Institutional Review Board Statement
Informed Consent Statement
Data Availability Statement
Acknowledgments
Conflicts of Interest
References
- Davies, J.E.; Behroozian, S. An Ancient Solution to a Modern Problem. Mol. Microbiol. 2020, 113, 546–549. [Google Scholar] [CrossRef]
- Viseras, C.; Sánchez-Espejo, R.; Palumbo, R.; Liccardi, N.; García-Villén, F.; Borrego-Sánchez, A.; Massaro, M.; Riela, S.; López-Galindo, A. Clays in Cosmetics and Personal Care Products. Clays Clay Miner. 2021, 69, 561–575. [Google Scholar] [CrossRef]
- Serri, C.; de Gennaro, B.; Catalanotti, L.; Cappelletti, P.; Langella, A.; Mercurio, M.; Mayol, L.; Biondi, M. Surfactant-Modified Phillipsite and Chabazite as Novel Excipients for Pharmaceutical Applications? Microporous Mesoporous Mater. 2016, 224, 143–148. [Google Scholar] [CrossRef]
- Ewis, D.; Ba-Abbad, M.M.; Benamor, A.; El-Naas, M.H. Adsorption of Organic Water Pollutants by Clays and Clay Minerals Composites: A Comprehensive Review. Appl. Clay Sci. 2022, 229, 106686. [Google Scholar] [CrossRef]
- Uddin, M.K. A Review on the Adsorption of Heavy Metals by Clay Minerals, with Special Focus on the Past Decade. J. Chem. Eng 2017, 308, 438–462. [Google Scholar] [CrossRef]
- Janani, F.Z.; Taoufik, N.; Khiar, H.; Boumya, W.; Elhalil, A.; Sadiq, M.; Puga, A.V.; Barka, N. Nanostructured Layered Double Hydroxides Based Photocatalysts: Insight on Synthesis Methods, Application in Water Decontamination/Splitting and Antibacterial Activity. Surf. Interfaces 2021, 25, 101263. [Google Scholar] [CrossRef]
- Cheikh, D.; Majdoub, H.; Darder, M. An Overview of Clay-Polymer Nanocomposites Containing Bioactive Compounds for Food Packaging Applications. Appl. Clay Sci. 2022, 216, 106335. [Google Scholar] [CrossRef]
- Nadziakiewicza, M.; Kehoe, S.; Micek, P. Physico-Chemical Properties of Clay Minerals and Their Use as a Health Promoting Feed Additive. Animals 2019, 9, 714. [Google Scholar] [CrossRef]
- Murugesan, S.; Scheibel, T. Copolymer/Clay Nanocomposites for Biomedical Applications. Adv. Funct. Mater. 2020, 30, 1908101. [Google Scholar] [CrossRef]
- Gaharwar, A.K.; Cross, L.M.; Peak, C.W.; Gold, K.; Carrow, J.K.; Brokesh, A.; Singh, K.A. 2D Nanoclay for Biomedical Applications: Regenerative Medicine, Therapeutic Delivery, and Additive Manufacturing. Adv. Mater. 2019, 31, 1900332. [Google Scholar] [CrossRef]
- de Sousa Rodriguez, L.A.; Figueiras, A.; Veiga, F.; Mendes de Freitas, R.; Cunha Nunes, L.C.; da Silva Filho, E.C.; da Silva Leite, C.M. The Systems Containing Clays and Clay Minerals from Modified Drug Release: A Review. Colloids Surf. B Biointerfaces 2013, 103, 642–651. [Google Scholar] [CrossRef]
- García-Villén, F.; Ruiz-Alonso, S.; Lafuente-Merchan, M.; Gallego, I.; Sainz-Ramos, M.; Saenz-del-Burgo, L.; Pedraz, J.L. Clay Minerals as Bioink Ingredients for 3D Printing and 3D Bioprinting: Application in Tissue Engineering and Regenerative Medicine. Pharmaceutics 2021, 13, 1806. [Google Scholar] [CrossRef]
- García-Villén, F.; Viseras, C. Clay-Based Pharmaceutical Formulations and Drug Delivery Systems. Pharmaceutics 2020, 12, 1142. [Google Scholar] [CrossRef] [PubMed]
- Zhang, Y.; Liu, X.; Geng, C.; Shen, H.; Zhang, Q.; Miao, Y.; Wu, J.; Ouyang, R.; Zhou, S. Two Hawks with One Arrow: A Review on Bifunctional Scaffolds for Photothermal Therapy and Bone Regeneration. Nanomaterials 2023, 13, 551. [Google Scholar] [CrossRef] [PubMed]
- Dawson, J.I.; Oreffo, R.O.C. Clay: New Opportunities for Tissue Regeneration and Biomaterial Design. Adv. Mater. 2013, 25, 4069–4086. [Google Scholar] [CrossRef]
- Belghazdis, M.; Hachem, E.-K. Clay and Clay Minerals: A Detailed Review. Int. J. Recent Technol. Appl. Sci. 2022, 4, 54–75. [Google Scholar] [CrossRef]
- Bianchi, E.; Vigani, B.; Viseras, C.; Ferrari, F.; Rossi, S.; Sandri, G. Inorganic Nanomaterials in Tissue Engineering. Pharmaceutics 2022, 14, 1127. [Google Scholar] [CrossRef]
- Taviot-Guého, C.; Prevot, V.; Forano, C.; Renaudin, G.; Mousty, C.; Leroux, F. Tailoring Hybrid Layered Double Hydroxides for the Development of Innovative Applications. Adv. Funct. Mater. 2018, 28, 1703868. [Google Scholar] [CrossRef]
- Villa, C.C.; Galus, S.; Nowacka, M.; Magri, A.; Petriccione, M.; Gutiérrez, T.J. Molecular Sieves for Food Applications: A Review. Trends Food Sci. Technol. 2020, 102, 102–122. [Google Scholar] [CrossRef]
- Sandri, G.; Bonferoni, M.C.; Rossi, S.; Ferrari, F.; Aguzzi, C.; Viseras, C.; Caramella, C. Clay Minerals for Tissue Regeneration, Repair, and Engineering. In Wound Healing Biomaterials; Woodhead Publishing: Sawston, UK, 2016; Volume 2, pp. 385–402. [Google Scholar]
- Viseras, C.; Cerezo, P.; Sánchez-Espejo, R.; Salcedo, I.; Aguzzi, C. Current Challenges in Clay Minerals for Drug Delivery. Appl. Clay Sci. 2010, 48, 291–295. [Google Scholar] [CrossRef]
- Lopez-Galindo, A.; Viseras, C.; Aguzzi, C.; Cerezo, P. Pharmaceutical and Cosmetic Uses of Fibrous Clays. In Developments in Clay Science; Elsevier: Amsterdam, The Netherlands, 2011; Volume 3, pp. 299–324. ISBN 978-0-444-53607-5. [Google Scholar]
- Carretero, M.I.; Pozo, M. Clay and Non-Clay Minerals in the Pharmaceutical Industry. Appl. Clay Sci. 2009, 46, 73–80. [Google Scholar] [CrossRef]
- Singh Khurana, I.; Kaur, S.; Kaur, H.; Kaur Khurana, R. Multifaceted Role of Clay Minerals in Pharmaceuticals. Future Sci. OA 2015, 1, 1–9. [Google Scholar] [CrossRef]
- Krajišnik, D.; Dakovic, A.; Milic, J.; Markovic, M. Zeolites as Potential Drug Carriers. In Modified Clay and Zeolite Nanocomposite Materials; Elsevier: Amsterdam, The Netherlands, 2019; pp. 27–55. [Google Scholar]
- Awad, M.E.; El-Rahmany, M.M.; Ibric, S. Flow and Tableting Behaviors of Some Egyptian Kaolin Powders as Potential Pharmaceutical Excipients. Minerals 2020, 10, 23. [Google Scholar] [CrossRef]
- Yendluri, R.; Otto, D.P.; De Villiers, M.M.; Vinokurov, V.; Lvov, Y.M. Application of Halloysite Clay Nanotubes as a Pharmaceutical Excipient. Int. J. Pharm. 2017, 521, 267–273. [Google Scholar] [CrossRef] [PubMed]
- Hu, T.; Gu, Z.; Williams, G.R.; Strimaite, M.; Zha, J.; Zhou, Z.; Zhang, X.; Tan, C.; Liang, R. Layered Double Hydroxide-Based Nanomaterials for Biomedical Applications. Chem. Soc. Rev. 2022, 51, 6126–6176. [Google Scholar] [CrossRef]
- Carretero, M.I.; Pozo, M. Clay and Non-Clay Minerals in the Pharmaceutical and Cosmetic Industries Part II. Active Ingredients. Appl. Clay Sci. 2010, 47, 171–181. [Google Scholar] [CrossRef]
- Nuruzzaman, M.; Rahman, M.M.; Liu, Y.; Naidu, R. Nanoencapsulation, Nano-Guard for Pesticides: A New Window for Safe Application. J. Agric. Food Chem. 2016, 64, 1447–1483. [Google Scholar] [CrossRef]
- Das, P.; Manna, S.; Behera, A.K.; Shee, M.; Piyali, B.; Sharma, A.K. Current Synthesis and Characterization Techniques for Clay-Based Polymer Nano-Composites and Its Biomedical Applications: A Review. Environ. Res. 2022, 212, 113534. [Google Scholar] [CrossRef]
- Dong, J.; Cheng, Z.; Tan, S.; Zhu, Q. Clay Nanoparticles as Pharmaceutical Carriers in Drug Delivery Systems. Expert Opin. Drug Deliv. 2021, 18, 695–714. [Google Scholar] [CrossRef]
- Wang, R.; Li, H.; Ge, G.; Dai, N.; Rao, J.; Ran, H.; Zhang, Y. Montmorillonite-Based Two-Dimensional Nanocomposites: Preparation and Applications. Molecules 2021, 26, 2521. [Google Scholar] [CrossRef]
- Bee, S.-L.; Abdullah, M.A.A.; Bee, S.-T.; Sin, L.T.; Rahmat, A.R. Polymer Nanocomposites Based on Silylated-Montmorillonite: A Review. Prog. Polym. Sci. 2018, 85, 57–82. [Google Scholar] [CrossRef]
- Kevadiya, B.D.; Bajaj, H.C. The Layered Silicate, Montmorillonite (MMT) as a Drug Delivery Carrier. Key Eng. Mater. 2013, 571, 111–132. [Google Scholar] [CrossRef]
- Jain, S.; Datta, M. Oral Extended Release of Dexamethasone: Montmorillonite–PLGA Nanocomposites as a Delivery Vehicle. Appl. Clay Sci. 2015, 104, 182–188. [Google Scholar] [CrossRef]
- Leite, M.S.; Sodré, W.C.; de Lima, L.R.; Constantino, V.R.L.; Alcântara, A.C.S. Bionanocomposite Beads Based on Montmorillonite and Biopolymers as Potential Systems for Oral Release of Ciprofloxacin. Clays Clay Miner. 2021, 69, 547–560. [Google Scholar] [CrossRef]
- Salcedo, I.; Sandri, G.; Aguzzi, C.; Bonferoni, C.; Cerezo, P.; Sànchez-Espejo, R.; Viseras, C. Intestinal Permeability of Oxytetracycline from Chitosan-Montmorillonite Nanocomposites. Colloids Surf. B Biointerfaces 2014, 117, 441–448. [Google Scholar] [CrossRef]
- Sreekanth Reddy, O.; Subha, M.C.S.; Jithendra, T.; Madhavi, C.; Chowdoji Rao, K. Curcumin Encapsulated Dual Cross Linked Sodium Alginate/Montmorillonite Polymeric Composite Beads for Controlled Drug Delivery. J. Pharm. Anal. 2021, 11, 191–199. [Google Scholar] [CrossRef]
- Zhao, Y.; Li, J.; Han, X.; Tao, Q.; Liu, S.; Jiang, G.; Zhu, G.; Yang, F.; Lv, Z.; Chen, Y.; et al. Dual Controlled Release Effect of Montmorillonite Loaded Polymer Nanoparticles for Ophthalmic Drug Delivery. Appl. Clay Sci. 2019, 180, 105167. [Google Scholar] [CrossRef]
- Sharifzadeh, G.; Hezaveh, H.; Muhamad, I.I.; Hashim, S.; Khairuddin, N. Montmorillonite-Based Polyacrylamide Hydrogel Rings for Controlled Vaginal Drug Delivery. Mater. Sci. Eng. C 2020, 110, 110609. [Google Scholar] [CrossRef]
- Saha, K.; Butola, B.S.; Joshi, M. Drug-loaded Polyurethane Clay Nanocomposite Nanofibers for Topical Drug-delivery. J. Appl. Polym. Sci. 2014, 131, 10. [Google Scholar] [CrossRef]
- Faccendini, A.; Ruggeri, M.; Miele, D.; Rossi, S.; Bonferoni, M.C.; Aguzzi, C.; Grisoli, P.; Viseras, C.; Vigani, B.; Sandri, G.; et al. Norfloxacin-Loaded Electrospun Scaffolds: Montmorillonite Nanocomposite vs. Free Drug. Pharmaceutics 2020, 12, 325. [Google Scholar] [CrossRef]
- Sajjad, W.; Khan, T.; Ul-Islam, M.; Khan, R.; Hussain, Z.; Khalid, A.; Wahid, F. Development of Modified Montmorillonite-Bacterial Cellulose Nanocomposites as a Novel Substitute for Burn Skin and Tissue Regeneration. Carbohydr. Polym. 2019, 206, 548–556. [Google Scholar] [CrossRef]
- Olad, A.; Azhar, F.F. The Synergetic Effect of Bioactive Ceramic and Nanoclay on the Properties of Chitosan–Gelatin/Nanohydroxyapatite–Montmorillonite Scaffold for Bone Tissue Engineering. Ceram. Int. 2014, 40, 10061–10072. [Google Scholar] [CrossRef]
- Mohan, A.; Girdhar, M.; Kumar, R.; Chaturvedi, H.S.; Vadhel, A.; Solanki, P.R.; Kumar, A.; Kumar, D.; Mamidi, N. Polyhydroxybutyrate-Based Nanocomposites for Bone Tissue Engineering. Pharmaceuticals 2021, 14, 1163. [Google Scholar] [CrossRef]
- Sheng, R.; Chen, J.; Wang, H.; Luo, Y.; Liu, J.; Chen, Z.; Mo, Q.; Chi, J.; Ling, C.; Tan, X.; et al. Nanosilicate-Reinforced Silk Fibroin Hydrogel for Endogenous Regeneration of Both Cartilage and Subchondral Bone. Adv. Healthc. Mater. 2022, 11, 2200602. [Google Scholar] [CrossRef]
- Gkouma, E.; Gianni, E.; Avgoustakis, K.; Papoulis, D. Applications of Halloysite in Tissue Engineering. Appl. Clay Sci. 2021, 214, 106291. [Google Scholar] [CrossRef]
- Same, S.; Nakhjavani, S.A.; Samee, G.; Navidi, G.; Jahanbani, Y.; Davaran, S. Halloysite Clay Nanotube in Regenerative Medicine for Tissue and Wound Healing. Ceram. Int. 2022, 48, 31065–31079. [Google Scholar] [CrossRef]
- Massaro, M.; Colletti, C.; Lazzara, G.; Riela, S. The Use of Some Clay Minerals as Natural Resources for Drug Carrier Applications. J. Funct. Biomater. 2018, 9, 58. [Google Scholar] [CrossRef]
- Liao, J.; Wang, H.; Liu, N.; Yang, H. Functionally Modified Halloysite Nanotubes for Personalized Bioapplications. Adv. Colloid Interface Sci. 2023, 311, 102812. [Google Scholar] [CrossRef] [PubMed]
- Carazo, E.; Sandri, G.; Cerezo, P.; Lanni, C.; Ferrari, F.; Bonferoni, C.; Viseras, C.; Aguzzi, C. Halloysite Nanotubes as Tools to Improve the Actual Challenge of Fixed Doses Combinations in Tuberculosis Treatment. J. Biomed. Mater. Res. Part A 2019, 107, 1513–1521. [Google Scholar] [CrossRef] [PubMed]
- Borges de Macedo, J.; Bonametti Olivato, J.; Marini, J.; Aenishanslin, J.; Pianaro, S.A.; Colerato Ferrari, P. Halloysite/Cellulose Derivatives-Based Bionanocompositesfor Controlled Naproxen Delivery. J. Appl. Polym. Sci. 2022, 139, e51889. [Google Scholar] [CrossRef]
- Nyankson, E.; Aboagye, S.O.; Efavi, J.K.; Agyei-Tuffour, B.; Paemka, L.; Asimeng, B.O.; Balapangu, S.; Arthur, P.K.; Tiburu, E.K. Chitosan-Coated Halloysite Nanotubes As Vehicle for Controlled Drug Delivery to MCF-7 Cancer Cells In Vitro. Materials 2021, 14, 2837. [Google Scholar] [CrossRef]
- Yar Saleh, M.; Prajapati, N.; DeCoster, M.A.; Lvov, Y. Tagged Halloysite Nanotubes as a Carrier for Intercellular Delivery in Brain Microvascular Endothelium. Front. Bioeng. Biotechnol. 2020, 8, 451. [Google Scholar] [CrossRef] [PubMed]
- Massaro, M.; Campofelice, A.; Colletti, C.G.; Lazzara, G.; Noto, R.; Riela, S. Functionalized Halloysite Nanotubes_ Efficient Carrier Systems for Antifungine Drugs. Appl. Clay Sci. 2018, 160, 186–192. [Google Scholar] [CrossRef]
- Kruglikov, A.; Vasilchenko, A.; Kasprzhitskii, A.; Lazorenko, G. Atomic-Level Understanding of Interface Interactions in a Halloysite Nanotubes–PLA Nanocomposite. RSC Adv. 2019, 9, 39505. [Google Scholar] [CrossRef]
- Alakrach, A.M.; Noriman, N.Z.; Dahham, O.S.; Hamzah, R.; Shayfull, Z.; Idrus, S.Z.S. The Effects of Tensile Properties of PLA/HNTs-ZrO2 Bionanocomposites. J. Phys. Conf. Ser. 2018, 1019, 012066. [Google Scholar] [CrossRef]
- Montava-Jorda, S.; Chacon, V.; Lascano, D.; Sanchez-Nacher, L.; Montanes, N. Manufacturing and Characterization of Functionalized Aliphatic Polyester from Poly(Lactic Acid) with Halloysite Nanotubes. Polymers 2019, 11, 1314. [Google Scholar] [CrossRef] [PubMed]
- Kim, Y.H.; Kwon, S.H.; Choi, H.J.; Choi, K.; Kao, N.; Bhattacharya, S.N.; Gupta, R.K. Thermal, Mechanical, and Rheological Characterization of Polylactic Acid/Halloysite Nanotube Nanocomposites. J. Macromol. Sci. B 2016, 55, 680–692. [Google Scholar] [CrossRef]
- Eryildiz, M.; Altan, M. Fabrication of Polylactic Acid/Halloysite Nanotube Scaffolds by Foam Injection Molding for Tissue Engineering. Polym. Compos. 2020, 41, 757–767. [Google Scholar] [CrossRef]
- Sandri, G.; Aguzzi, C.; Rossi, S.; Bonferoni, M.C.; Bruni, G.; Boselli, C.; Icaro Cornaglia, A.; Riva, F.; Viseras, C.; Caramella, C.; et al. Halloysite and Chitosan Oligosaccharide Nanocomposite for Wound Healing. Acta Biomater. 2017, 57, 216–224. [Google Scholar] [CrossRef]
- Koosha, M.; Raoufi, M.; Moravvej, H. One-Pot Reactive Electrospinning of Chitosan/PVA Hydrogel Nanofibers Reinforced by Halloysite Nanotubes with Enhanced Fibroblast Cell Attachment for Skin Tissue Regeneration. Colloids Surf. B Biointerfaces 2019, 179, 270–279. [Google Scholar] [CrossRef]
- Jaberifard, F.; Ghorbani, M.; Arsalani, N.; Mostafavi, H. A Novel Insoluble Film Based on Crosslinked-Starch with Gelatin Containing ZnO-Loaded Halloysite Nanotube and Bacterial Nanocellulose for Wound Healing Applications. Appl. Clay Sci. 2022, 230, 106667. [Google Scholar] [CrossRef]
- Zhao, P.; Feng, Y.; Zhou, Y.; Tan, C.; Liu, M. Gold@Halloysite Nanotubes-Chitin Composite Hydrogel with Antibacterial and Hemostatic Activity for Wound Healing. Bioact. Mater. 2023, 20, 355–367. [Google Scholar] [CrossRef]
- Machowska, A.; Klara, J.; Ledwójcik, G.; Wójcik, K.; Dulińska-Litewka, J.; Karewicz, A. Clindamycin-Loaded Halloysite Nanotubes as the Antibacterial Component of Composite Hydrogel for Bone Repair. Polymers 2022, 14, 5151. [Google Scholar] [CrossRef] [PubMed]
- Same, S.; Kadkhoda, J.; Navidi, G.; Abedi, F.; Aghazadeh, M.; Milani, M.; Akbarzadeh, A.; Davaran, S. The Fabrication of Halloysite Nanotube-Based Multicomponent Hydrogel Scaffolds for Bone Healing. J. Appl. Biomater. 2022, 20, 22808000221111875. [Google Scholar] [CrossRef] [PubMed]
- Cao, L.; Xie, W.; Cui, H.; Xiong, Z.; Tang, Y.; Zhang, X.; Feng, Y. Fibrous Clays in Dermopharmaceutical and Cosmetic Applications: Traditional and Emerging Perspectives. Int. J. Pharm. 2022, 625, 122097. [Google Scholar] [CrossRef] [PubMed]
- Ruiz-Hitzky, E.; Darder, M.; Fernandes, F.M.; Wicklein, B.; Alcântara, A.C.S.; Aranda, P. Fibrous Clays Based Bionanocomposites. Prog. Polym. Sci. 2013, 38, 1392–1414. [Google Scholar] [CrossRef]
- Kim, M.H.; Choi, G.; Elzatahry, A.; Vinu, A.; Choy, Y.B.; Choy, J.-H. Review of Clay-Drug Hybrid Materials for Biomedical Applications: Administration Routes. Clays Clay Miner. 2016, 64, 115–130. [Google Scholar] [CrossRef] [PubMed]
- Mohd Zaini, N.A.; Ismail, H.; Rusli, A. Short Review on Sepiolite-Filled Polymer Nanocomposites. Polym. Plast. Technol. Eng. 2017, 56, 1665–1679. [Google Scholar] [CrossRef]
- Mura, P.; Maestrelli, F.; Aguzzi, C.; Viseras, C. Hybrid Systems Based on “Drug—In Cyclodextrin—In Nanoclays” for Improving Oxaprozin Dissolution Properties. Int. J. Pharm. 2016, 509, 8–15. [Google Scholar] [CrossRef]
- Maestrelli, F.; Cirri, M.; Garcia-Villen, F.; Borrego-Sánchez, A.; Viseras, C.; Mura, P. Tablets of “Hydrochlorothiazide in Cyclodextrin in Nanoclay”: A New Nanohybrid System with Enhanced Dissolution Properties. Pharmaceutics 2020, 12, 104. [Google Scholar] [CrossRef]
- Rebitski, E.P.; Alcântara, A.C.S.; Darder, M.; Cansian, R.L.; Gómez-Hortigüela, L.; Pergher, S.B.C. Functional Carboxymethylcellulose/Zein Bionanocomposite Films Based on Neomycin Supported on Sepiolite or Montmorillonite Clays. ACS Omega 2018, 3, 13538–13550. [Google Scholar] [CrossRef] [PubMed]
- Borrego-Sánchez, A.; Carazo, E.; Aguzzi, C.; Viseras, C.; Sainz-Diaz, C.I. Biopharmaceutical Improvement of Praziquantel by Interaction with Montmorillonite and Sepiolite. Appl. Clay Sci. 2018, 160, 173–179. [Google Scholar] [CrossRef]
- Gutschmidt, D.; Shankar Hazra, R.; Zhou, X.; Xu, X.; Sabzi, M.; Jiang, L. Electrospun, Sepiolite-Loaded Poly(Vinyl Alcohol)/Soy Protein Isolate Nanofibers: Preparation, Characterization, and Their Drug Release Behavior. Int. J. Pharm. 2021, 594, 120172. [Google Scholar] [CrossRef]
- Killeen, D.; Frydrych, M.; Chen, B. Porous Poly(Vinyl Alcohol)/Sepiolite Bone Scaffolds: Preparation, Structure and Mechanical Properties. Mater. Sci. Eng. C 2012, 32, 749–757. [Google Scholar] [CrossRef]
- Dutta, J.; Devi, N. Preparation, Optimization, and Characterization of Chitosan-Sepiolite Nanocomposite Films for Wound Healing. Int. J. Biol. Macromol. 2021, 186, 244–254. [Google Scholar] [CrossRef] [PubMed]
- Chen, P.; Xie, F.; McNally, T. Understanding the Effects of Montmorillonite and Sepiolite on the Properties of Solution-cast Chitosan and Chitosan/Silk Peptide Composite Films. Polym. Int. 2021, 70, 527–535. [Google Scholar] [CrossRef]
- Rehmat, S.; Rizvi, N.B.; Khan, S.U.; Ghaffar, A.; Islam, A.; Khan, R.U.; Mehmood, A.; Butt, H.; Rizwan, M. Novel Stimuli-Responsive Pectin-PVP-Functionalized Clay Based Smart Hydrogels for Drug Delivery and Controlled Release Application. Front. Mater. 2022, 9, 823545. [Google Scholar] [CrossRef]
- Damasceno Junior, E.; Ferreira de Almeida, J.M.; do Nascimento Silva, I.; Moreira de Assis, M.L.; Maciel dos Santos, L.; Dias, E.F.; da Silva, F.E.; Fernandes, N.S.; Ribeiro da Silva, D. Obtaining and Applying Nanohybrid Palygorskite-Rifampicin in the PH-Responsive Release of the Tuberculostatic Drug. Langmuir 2020, 36, 10251–10269. [Google Scholar] [CrossRef]
- Damasceno Junior, E.; Ferreira de Almeida, J.M.; do Nascimento Silva, I.; Moreira de Assis, M.L.; Maciel dos Santos, L.; Dias, E.F.; Bezerra Aragao, V.E.; Mafra Verissimo, L.; Fernandes, N.S.; Ribeiro da Silva, D. PH-Responsive Release System of Isoniazid Using Palygorskite as a Nanocarrier. J. Drug Deliv. Sci. Technol. 2020, 55, 101399. [Google Scholar] [CrossRef]
- Carazo, E.; Borrego-Sánchez, A.; Garcia-Villen, F.; Sànchez-Espejo, R.; Viseras, C.; Cerezo, P.; Aguzzi, C. Adsorption and Characterization of Palygorskite-Isoniazid Nanohybrids. Appl. Clay Sci. 2018, 160, 180–185. [Google Scholar] [CrossRef]
- Zhang, Z.; Zhang, X.; Fu, Z.; Cao, L.; Xiong, Z.; Tang, Y.; Feng, Y. Fibrous Palygorskite Clays as Versatile Nanocarriers for Skin Delivery of Tea Tree Oils in Efficient Acne Therapy. Int. J. Pharm. 2022, 623, 121903. [Google Scholar] [CrossRef]
- Ruggeri, M.; Sánchez-Espejo, R.; Casula, L.; de Melo Barbosa, R.; Sandri, G.; Cardia, M.C.; Lai, F.; Viseras, C. Clay-Based Hydrogels as Drug Delivery Vehicles of Curcumin Nanocrystals for Topical Application. Pharmaceutics 2022, 14, 2836. [Google Scholar] [CrossRef]
- Ruggeri, M.; Sànchez-Espejo, R.; Casula, L.; Sandri, G.; Perioli, L.; Cardia, M.C.; Lai, F.; Viseras, C. Bentonite-and Palygorskite-Based Gels for Topical Drug Delivery Applications. Pharmaceutics 2023, 15, 1253. [Google Scholar] [CrossRef]
- Lobato-Aguilar, H.; Uribe-Calderon, J.A.; Herrera-Kao, W.; Duarte-Aranda, S.; Baas-Lopez, J.M.; Escobar-Morales, B.; Cauich-Rodriguez, J.V.; Cervantes-Uc, J.M. Synthesis, Characterization and Chlorhexidine Release from Either Montmorillonite or Palygorskite Modified Organoclays for Antibacterial Applications. J. Drug Deliv. Sci. Technol. 2018, 46, 452–460. [Google Scholar] [CrossRef]
- Yahia, Y.; Garcia-Villen, F.; Djelad, A.; Setti Belaroui, L.; Sànchez-Espejo, R.; Sassi, M.; López-Galindo, A.; Viseras, C. Crosslinked Palygorskite-Chitosan Beads as Diclofenac Carriers. Appl. Clay Sci. 2019, 180, 105169. [Google Scholar] [CrossRef]
- de Carvalho Freitas, A.K.; Saorin Puton, B.M.; da Silva Peres, A.P.; Cansian, R.L.; Castella Pergher, S.B.; Acchar, W. Palygorskite Sheets Prepared via Tape Casting for Wound Healing Applications. Int. J. Appl. Ceram. Technol. 2020, 17, 320–326. [Google Scholar] [CrossRef]
- Wang, D.; Zhu, L.; Qiu, J.; Zhu, P. Poly(Acrylic Acid)/Palygorskite Microgel via Radical Polymerization in Aqueous Phase for Reinforcing Poly(Vinyl Alcohol) Hydrogel. Appl. Clay Sci. 2020, 185, 105421. [Google Scholar] [CrossRef]
- Zhang, H.; Wang, W.; Ding, J.; Lu, Y.; Xu, J.; Wang, A. An Upgraded and Universal Strategy to Reinforce Chitosan/Polyvinylpyrrolidone Film by Incorporating Active Silica Nanorods Derived from Natural Palygorskite. Int. J. Biol. Macromol. 2020, 165, 1276–1285. [Google Scholar] [CrossRef]
- Carniato, F.; Gatti, G.; Bisio, C. An Overview of the Recent Synthesis and Functionalization Methods of Saponite Clay. New J. Chem. 2020, 44, 9969–9980. [Google Scholar] [CrossRef]
- Barakan, S.; Aghazadeh, V. The Advantages of Clay Mineral Modification Methods for Enhancing Adsorption Efficiency in Wastewater Treatment: A Review. Environ. Sci. Pollut. Res. 2021, 28, 2572–2599. [Google Scholar] [CrossRef]
- Zhang, D.; Zhou, C.H.; Lin, C.-X.; Tong, D.S.; Yu, W.-H. Synthesis of Clay Minerals. Appl. Clay Sci. 2010, 50, 1–11. [Google Scholar] [CrossRef]
- Zhou, C.H. Emerging Trends and Challenges in Synthetic Clay-Based Materials and Layered Double Hydroxides. Appl. Clay Sci. 2010, 48, 1–4. [Google Scholar] [CrossRef]
- Vicente, I.; Salagre, P.; Cesteros, Y.; Medina, F.; Sueiras, J.E. Microwave-Assisted Synthesis of Saponite. Appl. Clay Sci. 2010, 48, 26–31. [Google Scholar] [CrossRef]
- Rao, M.M.; Reddy, B.R.; Jayalakshmi, M.; Jaya, V.S.; Sridhar, B. Hydrothermal Synthesis of Mg–Al Hydrotalcites by Urea Hydrolysis. Mater. Res. Bull. 2005, 40, 347–359. [Google Scholar] [CrossRef]
- Guo, Y.-P.; Long, T.; Song, Z.-F.; Zhu, Z.-A. Hydrothermal Fabrication of ZSM-5 Zeolites: Biocompatibility, Drug Delivery Property, and Bactericidal Property. J. Biomed. Mater. Res. Part B 2014, 102B, 583–591. [Google Scholar] [CrossRef]
- Bukhtiyarova, M.V. A Review on Effect of Synthesis Conditions on the Formation of Layered Double Hydroxides. J. Solid State Chem. 2019, 269, 494–506. [Google Scholar] [CrossRef]
- Wu, Q.; Meng, X.; Gao, X.; Xiao, F.-S. Solvent-Free Synthesis of Zeolites: Mechanism and Utility. Acc. Chem. Res. 2018, 51, 1396–1403. [Google Scholar] [CrossRef]
- Kiaee, G.; Dimitrakakis, N.; Sharifzadeh, S.; Kim, H.-J.; Avery, R.K.; Mollozadeh Moghaddam, K.; Haghniaz, R.; Pinar Yalcintas, E.; de Barros, N.R.; Karamikamkar, S.; et al. Laponite-Based Nanomaterials for Drug Delivery. Adv. Healthc. Mater. 2022, 11, 2102054. [Google Scholar] [CrossRef] [PubMed]
- Tomás, H.; Alves, C.S.; Rodrigues, J. Laponite®: A Key Nanoplatform for Biomedical Applications? Nanomed. Nanotechnol. Biol. Med. 2018, 14, 2407–2420. [Google Scholar] [CrossRef] [PubMed]
- Das, S.S.; Neelam, S.S.; Hussain, K.; Singh, S.; Hussain, A.; Faruk, A.; Tebyetekerwa, M. Laponite-Based Nanomaterials for Biomedical Applications: A Review. Curr. Pharm. Des. 2019, 25, 424–443. [Google Scholar] [CrossRef] [PubMed]
- Rodrigo, M.J.; Cardiel, M.J.; Fraile, J.M.; Mendez-Martinez, S.; Martinez-Rincon, T.; Subias, M.; Polo, V.; Ruberte, J.; Ramirez, T.; Vispe, E.; et al. Brimonidine-LAPONITE® Intravitreal Formulation Has an Ocular Hypotensive and Neuroprotective Effect throughout 6 Months of Follow-up in a Glaucoma Animal Model. Biomater. Sci. 2020, 8, 6246. [Google Scholar] [CrossRef] [PubMed]
- Fraile, J.M.; Garcia-Martin, E.; Gil, C.; Mayoral, J.A.; Pablo, L.E.; Polo, V.; Prieto, E.; Vispe, E. Laponite as Carrier for Controlled in Vitro Delivery of Dexamethasone in Vitreous Humor Models. Eur. J. Pharm. Biopharm. 2016, 108, 83–90. [Google Scholar] [CrossRef] [PubMed]
- Adrover, A.; Paolicelli, P.; Petralito, S.; Muzio, L.D.; Trilli, J.; Cesa, S.; Tho, I.; Casadei, M.A. Gellan Gum/Laponite Beads for the Modified Release of Drugs: Experimental and Modeling Study of Gastrointestinal Release. Pharmaceutics 2019, 11, 187. [Google Scholar] [CrossRef] [PubMed]
- Jiang, T.; Chen, G.; Shi, X.; Guo, R. Hyaluronic Acid-Decorated Laponite® Nanocomposites for Targeted Anticancer Drug Delivery. Polymers 2019, 11, 137. [Google Scholar] [CrossRef] [PubMed]
- Teodorescu, M.; Morariu, S. Drug Delivery System Based on PVA and Clay for Potential Treatment of COVID-19. J. Polym. Res. 2022, 29, 67. [Google Scholar] [CrossRef]
- Ordikhani, F.; Dehghani, M.; Simchi, A. Antibiotic-Loaded Chitosan–Laponite Films for Local Drug Delivery by Titanium Implants: Cell Proliferation and Drug Release Studies. J. Mater. Sci. Mater. Med. 2015, 26, 269. [Google Scholar] [CrossRef] [PubMed]
- Li, T.; Liu, Z.; Xiao, M.; Yang, Z.; Liu, Z.; Zhou, X.; Wang, J. In Vitro and in Vivo Studies of a Gelatin/Carboxymethyl Chitosan/LAPONITE® Composite Scaffold for Bone Tissue Engineering. RSC Adv. 2017, 7, 54100. [Google Scholar] [CrossRef]
- Atrian, M.; Kharaziha, M.; Emadi, R.; Alihosseini, F. Silk-Laponite® Fibrous Membranes for Bone Tissue Engineering. Appl. Clay Sci. 2019, 174, 90–99. [Google Scholar] [CrossRef]
- Cidonio, G.; Alcala-Orozco, C.R.; Lim, K.S.; Glinka, M.; Mutreja, I.; Kim, Y.-H.; Dawson, J.I.; Woodfield, T.B.F.; Oreffo, R.O.C. Osteogenic and Angiogenic Tissue Formation in High Fidelity Nanocomposite Laponite-Gelatin Bioinks. Biofabrication 2019, 11, 035027. [Google Scholar] [CrossRef]
- Zhang, R.; Xie, L.; Wu, H.; Yang, T.; Zhang, Q.; Tian, Y.; Liu, Y.; Han, X.; Guo, W.; He, M.; et al. Alginate/Laponite Hydrogel Microspheres Co-Encapsulating Dental Pulp Stem Cells and VEGF for Endodontic Regeneration. Acta Biomater. 2020, 113, 305–316. [Google Scholar] [CrossRef]
- Boyer, C.; Figueiredo, L.; Pace, R.; Lesoeur, J.; Rouillon, T.; Le Visage, C.; Tassin, J.-F.; Weiss, P.; Guicheux, J.; Rethore, G. Laponite Nanoparticle-Associated Silated Hydroxypropylmethyl Cellulose as an Injectable Reinforced Interpenetrating Network Hydrogel for Cartilage Tissue Engineering. Acta Biomater. 2018, 65, 112–122. [Google Scholar] [CrossRef] [PubMed]
- Zhang, Y.; Fan, W.; Wang, K.; Wei, H.; Zhang, R.; Wu, Y. Novel Preparation of Au Nanoparticles Loaded Laponite Nanoparticles/ECM Injectable Hydrogel on Cardiac Differentiation of Resident Cardiac Stem Cells to Cardiomyocytes. J. Photochem. Photobiol. B Biol. 2019, 192, 49–54. [Google Scholar] [CrossRef] [PubMed]
- Wang, Z.; Hu, J.; Yu, J.; Chen, D. Preparation and Characterization of Nano-Laponite/PLGA Composite Scaffolds for Urethra Tissue Engineering. Mol. Biotechnol. 2020, 62, 192–199. [Google Scholar] [CrossRef]
- Mishra, G.; Dash, B.; Pandey, S. Layered Double Hydroxides_ A Brief Review from Fundamentals to Application as Evolving Biomaterials. Appl. Clay Sci. 2018, 153, 172–186. [Google Scholar] [CrossRef]
- de Sousa, A.L.M.D.; dos Santos, W.M.; de Souza, M.L.; Silva, L.C.P.B.B.; Yun, A.E.H.K.; Aguilera, C.S.B.; de França Chagas, B.; Rolim, L.A.; da Silva, R.M.F.; Neto, P.J.R. Layered Double Hydroxides as Promising Excipients for Drug Delivery Purposes. Eur. J. Pharm. Sci. 2021, 165, 105922. [Google Scholar] [CrossRef]
- Bi, X.; Zhang, H.; Dou, L. Layered Double Hydroxide-Based Nanocarriers for Drug Delivery. Pharmaceutics 2014, 6, 298–332. [Google Scholar] [CrossRef]
- Pavlovic, M. Surface Modification of Two-Dimensional Layered Double Hydroxide Nanoparticles with Biopolymers for Biomedical Applications. Adv. Drug Deliv. Rev. 2022, 191, 114590. [Google Scholar] [CrossRef] [PubMed]
- Davis, R., Jr.; Urbanowski, R.A., Jr.; Gaharwar, A.K. 2D Layered Nanomaterials for Therapeutics Delivery. Curr. Opin. Biomed. Eng. 2021, 20, 100319. [Google Scholar] [CrossRef] [PubMed]
- Ameena Shirin, V.K.; Sankar, R.; Johnson, A.P.; Gangadharappa, H.V.; Pramod, K. Advanced Drug Delivery Applications of Layered Double Hydroxide. J. Control. Release 2021, 330, 398–426. [Google Scholar] [CrossRef] [PubMed]
- Chakraborty, J.; Roychowdhury, S.; Sengupta, S.; Ghosh, S. Mg–Al Layered Double Hydroxide–Methotrexate Nanohybrid Drug Delivery System: Evaluation of Efficacy. Mater. Sci. Eng. C 2013, 33, 2168–2174. [Google Scholar] [CrossRef]
- Phan, V.H.G.; Mathiyalagan, R.; Nguyen, M.-T.; Tran, T.-T.; Murugesan, M.; Ho, T.-N.; Huong, H.; Yang, D.C.; Li, Y.; Thambi, T. Ionically Cross-Linked Alginate-Chitosan Core-Shell Hydrogel Beads for Oral Delivery of Insulin. Int. J. Biol. Macromol. 2022, 222, 262–271. [Google Scholar] [CrossRef]
- Muráth, S.; Dvorníková, N.; Moreno-Rodríguez, D.; Novotný, R.; Pospíšil, M.; Urbanová, M.; Brus, J.; Kovanda, F. Intercalation of Atorvastatin and Valsartan into Mg Al Layered Double Hydroxide Host Using a Restacking Procedure. Appl. Clay Sci. 2023, 231, 106717. [Google Scholar] [CrossRef]
- Gu, D.; Pan, H.; Xu, S.; Chen, W.; Zhu, R.; Jiang, W.; Pan, W. Construction and Evaluation of Hyaluronic Acid–Coated Flurbiprofen-Layered Double Hydroxide Ocular Drug Delivery System. AAPS PharmSciTech 2022, 23, 287. [Google Scholar] [CrossRef]
- Kleyi, P.E.; Mudaly, P.; Kesavan Pillai, S.; de Beer, M. Zn/Al Layered Double Hydroxides Nanostructure as Effective Controlled Release Vehicle of Nicotinic Acid for Topical Applications. Appl. Clay Sci. 2021, 215, 106304. [Google Scholar] [CrossRef]
- Bouaziz, Z.; Djebbi, M.A.; Soussan, L.; Janot, J.-M.; Amara, A.B.H.; Balme, S. Adsorption of Nisin into Layered Double Hydroxide Nanohybrids and In-Vitro Controlled Release. Mater. Sci. Eng. C 2017, 76, 673–683. [Google Scholar] [CrossRef]
- Abhari, Z.; Asefnejad, A.; Solati-Hashjin, M. Effect of Addition of Layered Double Hydroxides (LDH) on Mechanical and Biological Properties of Electrospun Polycaprolactone Scaffold. J. Polym. Res. 2022, 29, 348. [Google Scholar] [CrossRef]
- Ahmadi, S.; Shafiei, S.S.; Sabouni, F. Electrospun Nanofibrous Scaffolds of Polycaprolactone/Gelatin Reinforced with Layered Double Hydroxide Nanoclay for Nerve Tissue Engineering Applications. ACS Omega 2022, 7, 28351–28360. [Google Scholar] [CrossRef]
- Dehkordi, A.N.; Shafei, S.S.; Chehelgerdi, M.; Sabouni, F.; Sharifi, E.; Makvandi, P.; Nasrollahi, N. Highly Effective Electrospun Polycaprolactone/ Layered Double Hydroxide Nanofibrous Scaffold for Bone Tissue Engineering. J. Drug Deliv. Sci. Technol. 2022, 76, 103827. [Google Scholar] [CrossRef]
- Li, X.; Gong, P.; Li, Y.; Yu, J.; Wang, F.; Li, X.; Fan, Z.; Wang, Z. Double-Carrier Drug Delivery System Based on Polyurethane-Polyvinyl Alcohol/Layered Double Hydroxide Nanocomposite Hydrogel. Mater. Lett. 2019, 243, 1–4. [Google Scholar] [CrossRef]
- Belgheisi, G.; Nazarpak, M.H.; Hashjin, M.S. Bone Tissue Engineering Electrospun Scaffolds Based on Layered Double Hydroxides with the Ability to Release Vitamin D3: Fabrication, Characterization and in Vitro Study. Appl. Clay Sci. 2020, 185, 105434. [Google Scholar] [CrossRef]
- Cao, D.; Xu, Z.; Chen, Y.; Ke, Q.; Zhang, C.; Guo, Y. Ag-Loaded MgSrFe-Layered Double Hydroxide/Chitosan Composite Scaffold with Enhanced Osteogenic and Antibacterial Property for Bone Engineering Tissue. J. Biomed. Mater. Res. B-Appl. Biomater. 2018, 106, 863–873. [Google Scholar] [CrossRef] [PubMed]
- Figueiredo, M.P.; Borrego-Sánchez, A.; García-Villén, F.; Miele, D.; Rossi, S.; Sandri, G.; Viseras, C.; Constantino, V.R.L. Polymer/Iron-Based Layered Double Hydroxides as Multifunctional Wound Dressings. Pharmaceutics 2020, 12, 1130. [Google Scholar] [CrossRef] [PubMed]
- Salguero, Y.; Valenti, L.; Rojas, R.; García, M.C. Ciprofloxacin-Intercalated Layered Double Hydroxide-in-Hybrid Films as Composite Dressings for Controlled Antimicrobial Topical Delivery. Mater. Sci. Eng. C 2020, 111, 110859. [Google Scholar] [CrossRef]
- Bacakova, L.; Vandrovcova, M.; Kopova, I.; Jirka, I. Applications of Zeolites in Biotechnology and Medicine—A Review. Biomater. Sci. 2018, 6, 974–989. [Google Scholar] [CrossRef] [PubMed]
- Krol, M. Natural vs Synthetic Zeolites. Crystals 2020, 10, 622. [Google Scholar] [CrossRef]
- Gatta, G.D.; Lotti, P. Systematics, Crystal Structures, and Occurrences of Zeolites. In Modified Clay and Zeolite Nanocomposite Materials; Elsevier: Amsterdam, The Netherlands, 2019; pp. 1–25. ISBN 978-0-12-814617-0. [Google Scholar]
- Kianfar, E. Zeolites: Properties, Applications, Modification and Selectivity. In Zeolites: Advances in Research and Applications; Nova Science Publishers, Inc.: Hauppauge, NY, USA, 2020; pp. 1–23. [Google Scholar]
- Eroglu, N.; Emekci, M.; Athanassiou, C.G. Applications of Natural Zeolites on Agriculture and Food Production. J. Sci. Food Agric. 2017, 97, 3487–3499. [Google Scholar] [CrossRef] [PubMed]
- Purnomo; Setyarini, P.H.; Sulistyaningsih, D. Zeolite-Based Biomaterials for Biomedical Application: A Review. AIP Conf. Proc. 2018, 1977, 030013. [Google Scholar] [CrossRef]
- Souza, I.M.S.; Sainz-Díaz, C.I.; Viseras, C.; Pergher, S.B. Adsorption Capacity Evaluation of Zeolites as Carrier of Isoniazid. Microporous Mesoporous Mater. 2020, 292, 109733. [Google Scholar] [CrossRef]
- Abd-Elsatar, A.G.; Farag, M.M.; Youssef, H.F.; Salih, S.A.; Mounier, M.M.; El-Meliegy, E. Different Zeolite Systems for Colon Cancer Therapy: Monitoring of Ion Release, Cytotoxicity and Drug Release Behavior. Prog. Biomater. 2019, 8, 101–113. [Google Scholar] [CrossRef]
- Jakubowski, M.; Kucinska, M.; Ratajczak, M.; Pokora, M.; Murias, M.; Voelkel, A.; Sandomierski, M. Zinc Forms of Faujasite Zeolites as a Drug Delivery System for 6-Mercaptopurine. Microporous Mesoporous Mater. 2022, 343, 112194. [Google Scholar] [CrossRef]
- Aslani, Z.; Nazemi, N.; Rajabi, N.; Kharaziha, M.; Bakhsheshi-Rad, H.R.; Kasiri-Asgarani, M.; Najafinezhad, A.; Ismail, A.F.; Sharif, S.; Berto, F. Antibacterial Activity and Cell Responses of Vancomycin-Loaded Alginate Coating on ZSM-5 Scaffold for Bone Tissue Engineering Applications. Materials 2022, 15, 4786. [Google Scholar] [CrossRef] [PubMed]
- Azarfam, M.Y.; Nasirinezhad, M.; Naeim, H.; Zarrintaj, P.; Saeb, M. A Green Composite Based on Gelatin/Agarose/Zeolite as a Potential Scaffold for Tissue Engineering Applications. J. Compos. Sci. 2021, 5, 125. [Google Scholar] [CrossRef]
- Ninan, N.; Muthiah, M.; Park, I.-K.; Elain, A.; Wong, T.W.; Thomas, S.; Grohens, Y. In Vitro and In Vivo Evaluation of Pectin/Copper Exchanged Faujasite Composite Membranes. J. Biomed. Nanotechnol. 2015, 11, 1550–1567. [Google Scholar] [CrossRef]
- Wang, X.; Fan, G.; Guan, Q.; Zhao, L.; Sun, F.; Yang, H.; Zhao, J.; Zhang, J.; Wang, H.; Zhang, W.; et al. Hyaluronic Acid-Modified ZIF-8 Nano-Vehicle for Self-Adaption Release of Curcumin for the Treatment of Burns. ACS Appl. Nano Mater. 2022, 5, 16094–16107. [Google Scholar] [CrossRef]
- Doustdar, F.; Ghorbani, M. ZIF-8 Enriched Electrospun Ethyl Cellulose/Polyvinylpyrrolidone Scaffolds: The Key Role of Polyvinylpyrrolidone Molecular Weight. Carbohydr. Polym. 2022, 291, 119620. [Google Scholar] [CrossRef]
- Qi, Y.; Qian, K.; Chen, J.; Shi, Y.; Li, H.; Zhao, L. A Thermoreversible Antibacterial Zeolite-Based Nanoparticles Loaded Hydrogel Promotes Diabetic Wound Healing via Detrimental Factor Neutralization and ROS Scavenging. J. Nanobiotechnol. 2021, 19, 414. [Google Scholar] [CrossRef] [PubMed]
- Zakeri, N.; Rezaie, H.R.; Javadpour, J.; Kharaziha, M. Cisplatin Loaded Polycaprolactone—Zeolite Nanocomposite Scaffolds for Bone Cancer Treatment. J. Sci. Adv. Mater. Devices 2022, 7, 100377. [Google Scholar] [CrossRef]

| Layered Clays | Fibrous Clays |
|---|---|
| 1-nanodimensional particle | 2-nanodimensional particle |
| High charge density | Low charge density |
| High CEC | Low CEC |
| Low density silanol groups | High density silanol groups |
| High internal surface area | Low internal surface area |
| Particles in layer stacks | Particles in bundles |
| Swelling clay | Non-swelling and non-exfoliable clay |
| Clay Type | Polymer | Drug | Targeted Application | In Vitro/In Vivo Studies | Major Results of In Vitro/In Vivo Studies | Ref. |
|---|---|---|---|---|---|---|
| MMT | PLGA | Dexamethasone | Oral DD | - | - | [36] |
| ι-carrageenan/gelatin | Ciprofloxacin | Oral DD | - | - | [37] | |
| Chitosan | Oxytetracycline | Oral DD | Toxicity and permeation on Caco-2 cells | All the samples showed good biocompatibility at the studied concentrations. Moreover, the OXT loading into the nanocarriers did not cause cytotoxic effect on Caco-2 cell line | [38] | |
| Sodium alginate | Curcumin | Oral DD | - | - | [39] | |
| Eudragit®PO | Betaloxol hydrochloride | Ophthalmic DD | CAM-TBS irritation assay | The MMT-betaloxol system was well tolerated but showed slight irritation due to the intrinsic irritancy of the active pharmaceutical ingredient (API) adsorbed on the surface of nanoparticles. | [40] | |
| Polyacrilamide/NaCMC | Methylene blue (model) | Vaginal DD | Toxicity on human skin fibroblasts (HSF 1184) | The hydrogels proved to be biocompatible. A slight decrease in cell viability was observed as the concentration of MMT was increased. This may be due to the blockage of most of the channels on cell membranes. | [41] | |
| Polyurethane | Chlorhexidine acetate | Skin TE | - | - | [42] | |
| Chitosan | Norfloxacin | Skin TE | Toxicity on normal human dermal fibroblasts (NHDF) | The scaffolds supported cell viability and proliferation after 6 days. The loading of norfloxacin caused a significant decrease in cell viability which could be completely attributed to the drug and not to the scaffold. | [43] | |
| Bacterial cellulose | - | Skin TE | Evaluation of wound healing activity on mice model | The wound healing activity in animals treated with nanocomposites was increased, together with tissue regeneration, vascularization and re-epithelialization | [44] | |
| Chitosan/gelatin | - | Bone TE | - | - | [45] | |
| Polyhydroxybutyrate | - | Bone TE | Toxicity on lymphocites | The addition of modified MMT increased cell viability compared to the polymer alone, with the greatest increase showed with the addition of 7% MMT. | [46] | |
| Silk fibroin | - | Bone/Cartilage TE | Toxicity on BMSCs and chondrocytes; Osteochondral regeneration on white rabbits | The MMT-reinforced SF hydrogel showed good cytocompatibility, as well as the bioactivities to induce osteogenesis. In vivo, SF-MMT treated groups presented a better cartilage regeneration, a more mature hyaline cartilage formation, an enhanced and integrated subchondral bone regeneration, and a more vertical-aligned arrangement compared, indicating a more physiological structure of regenerative cartilage | [47] | |
| HNT | - | Isoniazid | Oral DD | Toxicity and permeability on Caco-2 | INH-loaded HNT showed good biocompatibility at the concentrations studied (up to 1233 μg/mL), with improved cell proliferation. Permeability tests showed that INH transport across cellular membranes was greatly enhanced and the drug encapsulated into nanohybrid was effectively internalized by the cells | [52] |
| EC/HPMC | Naproxen | Oral DD | - | - | [53] | |
| Chitosan | Curcumin | Targeted DD (breast cancer) | Toxicity on MCF-7 | After 24 h of incubation, the HNT-treated cells recorded cell viability comparable with the control group (94%). The combination of curcumin and HNT increases cell viability compared to the pure drug. | [54] | |
| - | Rhodamin/ionomycine (model) | - | Toxicity and Ca2+ response on BMVECs | HNT-ionomycin nanocapsules showed a gradual influx of Ca2+ and higher delivery of ionomycin in the cells, which was much higher compared to HNT alone. | [55] | |
| - | Clotrimazol | Vaginal DD | - | - | [56] | |
| PLA | - | Skin TE | Toxicity on fibroblasts | Cell viability of the PLA/HNT scaffolds was improved compared with neat PLA foams. The highest cell viability ratio was obtained in scaffolds containing 3% HNT. | [61] | |
| Chitosan | - | Skin TE | Toxicity on fibroblasts; Wound healing activity on male rats | After 7 days of treatment, the histological analysis of threated samples allowed an early re-epithelialization process and an advanced degree of hemostasis and angiogenesis. Moreover, the presence of granulation tissue was observed. | [62] | |
| Chitosan/PVA | - | Skin TE | Toxicity and proliferation on fibroblasts | The biocompatibility of the nanocomposite samples containing HNT were higher than samples without HNT as well as control. Incorporation of HNT enhanced the cell attachment and proliferation on the samples. | [63] | |
| Dialdehyde corn starch/Gelatin/Bacterial nanocellulose | - | Skin TE | Toxicity and proliferation on NIH-3T3 fibroblasts | Cell viability in presence of films containing BC and HNT was increased, due to the electrostatically interaction of BC and HNT with growth factors and other ECM proteins, and to the capability of the scaffold to improve the hydrophilicity nature and protein absorption on its surface. | [64] | |
| Chitin | - | Skin TE | Toxicity on mouse fibroblast cell line L929; Wound healing ability in mice model | The HNT-chitin group had a wound healing effect with a reduced wound area compared to the control. It also showed has the highest collagen deposition density, which is similar to the control group. The hydrogel showed high hemostatic performance in mouse liver and tail bleeding, together with antibacterial activity. | [65] | |
| Sodium alginate/collagen | Clindamycin | Bone TE | Toxicity on Hs27 Human foreskin fibroblasts, WM793 human melanoma and human osteosarcoma (MG-63) cells | The cytocompatibility of materials containing HNT and their antibacterial effect on S. aureus was confirmed. | [66] | |
| PCL-PEG-PCL/Gelatin | - | Bone TE | Cell viability and proliferation on hDPSCs | The prepared composites were non-toxic even if a decrease in viability for scaffolds containing HNT of 6% was observed. The incorporation of HNT enhanced the surface volume of scaffolds and increased their roughness, providing superior interaction with cells. | [67] | |
| LDH | - | Methotrexate | Oral DD | Toxicity HCT-116 cell line | After 48 h incubation, at IC50 concentration of methotrexate (MTX), LDH–MTX nanohybrid was found to inhibit 50% of the cells, which is an increased value compared to the control. These results clearly demonstrated higher efficacy of LDH–MTX nanohybrid compared to the pure MTX. As expected, pristine LDH has shown little cytotoxicity as the control on the proliferation (~95%). | [123] |
| Alginate-Chitosan | Insulin | Oral DD | Biocompatibility CAM irritation assay | Core-shell hydrogel beads implanted chick embryo revealed good angiogenic response. Furthermore, the core–shell beads recovered from the chick embryo showed micro vascularity in the beads. | [124] | |
| - | Valsartan/Atorvastatin | Oral DD | - | - | [125] | |
| Hyaluronic acid | Flurbiprofen | Ophthalmic DD | In vivo pharmacokinetics and irritation study, ex vivo ocular distribution on white rabbits | Both in vivo ocular irritation test results and ocular pathological tissue section results illustrated that flurbiprofen-loaded LDH were not irritating to the eyes. The addition of hyaluronic acid could prolong the residence time of the drug in front of the cornea. In addition, bioavailability of flurbiprofen in the eyes could be improved. | [126] | |
| - | Nicotinic acid | Transdermic DD | - | - | [127] | |
| - | Nisin | - | - | - | [128] | |
| PCL/Gelatin | - | Nerve TE | Toxicity on human neuroblastoma SH-SY5Y cells | Cell migration and proliferation were enhanced in nanofibers containing LDH, as they led to more hydrophilicity and higher protein adsorption. | [130] | |
| PCL | - | Bone TE | Toxicity on human MG-63 osteoblast-like cells. | The LDH/PCL scaffold induced mineral deposition and osteogenic differentiation as evident by an increase in ALP activity in comparison with the pure PCL. | [131] | |
| Polyurethane/PVA | Enoxacin | Skin TE | - | - | [132] | |
| PCL | Vitamin D3 | Bone TE | Toxicity, cell adhesion, proliferation on MG-63 cell line | The addition of vitamin D3-LDH nanohybrid showed a great influence on improving cells adhesion to the scaffold surface, their spreading and the attachment of cells to each other. | [133] | |
| Chitosan | Bone TE | Toxicity on hBMSC cells | The in vitro cell tests reveal that all the LDH composite scaffolds exhibit excellent cytocompatibility. The presence of Ag and Sr contribute to osteogenic activity and antibacterial property, respectively. The released Sr2+ ions enhance the ALP activity, promote the ECM mineralization, and increase the expression levels of osteogenic-related RUNX2 and BMP-2. | [134] | ||
| PEBA | Naproxen | Skin TE | Toxicity on NHDF | The incorportation of LDH in PEBA displayed an improved biological response in comparison to the pristine polymer. The intercalation of naproxenate into Mg-LDH decreased the cytotoxicity of the drug in comparison with the pristine powder and its PEBA composite. | [135] | |
| Sodium hyaluronan | Cyprofloxacin | Skin TE | - | - | [136] | |
| ZEO | - | Isoniazid | Oral DD | - | - | [143] |
| - | 5-fluorouracil | Oral DD | Toxicity on Caco-2 cells | The drug-loaded versions of zeolite showed significant cytotoxic towards a tumoral cell-line compared to the pristine zeolites. Notably, the presence of Al released from the zeolite did not improve the cytotoxic activity of the zeolite, contradicting the idea of the poisonous effect of Al. | [144] | |
| - | 6-mercaptopurin | Oral DD | Toxicity on Mcf-7 cells | The tested materials containing 6-mercaptopurin released the drug and affected cancer cell viability, as opposed to unloaded zeolites. Two different zeolites were tested, with zeolite Y that released the drug (88%) more efficiently than zeolite X (78%) after 30 h incubation. | [145] | |
| PCL | Cisplatin | Bone TE | Toxicity on MG63 cells | the addition of 20% Zeol increased the in vitro bioactivity making it a suitable option for bone tissue engineering | [152] | |
| Alginate | Vancomycin | Bone TE | Toxicity on MG63 cells | After 7 days of culture, osteoblast cells were attached and proliferating, with a strong anibacterial effect given by the presence of vancomycin. | [146] | |
| Gelatin/Agarose | pomegranate peel extract | Skin TE | Toxicity on L929 mouse fibroblast cell line | The sample contaning 0.5% zeolite displayed a slightly higher cell proliferation compared to other samples. The zeolite addition up to 2% did not affect the hydrogel biocompatibility and cell proliferation. | [147] | |
| Pectin | Skin TE | Toxicity on NIH 3T3 fibroblasts; Wound healing on male rats | Pectin containing 1% of Cu-exchanged Faujasite exhibited excellent antibacterial activity and cell viability and aided in improving wound healing and re-epithelialization in Sprague Dawley rats. | [148] | ||
| Hyaluronic acid | Curcumin | Skin TE | Toxicity on mouse fibroblasts L929; Wound healing on mice model | The application in wounds in vivo shows that the scaffold can promote the proliferation of fibroblasts and accelerate angiogenesis. Importantly, histological analysis showed normal collagen density compared to free curcumin and control groups. | [149] | |
| EC/PVP | - | Skin TE | Toxicity on NIH3T3 fibroblasts | Scaffolds expressed higher percentages of cell proliferation compared with the control group. Moreover, the proliferation percent reached its highest value after 5 days of culture. Lowering the MW of PVP led to better results in terms of cell viability. | [150] | |
| Pluronic F127/Chitosan | - | Skin TE | Toxicity on HUVECs; Wound healing on mice model | The scaffolds containing zeolites showed improved proliferation, migration and angiogenesis. Furthermore, in vivo studies confirmed the formation of granulation tissue, re-epithelialization and collagen remodeling at the wound site, thereby accelerating the healing process | [151] |
Disclaimer/Publisher’s Note: The statements, opinions and data contained in all publications are solely those of the individual author(s) and contributor(s) and not of MDPI and/or the editor(s). MDPI and/or the editor(s) disclaim responsibility for any injury to people or property resulting from any ideas, methods, instructions or products referred to in the content. |
© 2023 by the authors. Licensee MDPI, Basel, Switzerland. This article is an open access article distributed under the terms and conditions of the Creative Commons Attribution (CC BY) license (https://creativecommons.org/licenses/by/4.0/).
Share and Cite
Nomicisio, C.; Ruggeri, M.; Bianchi, E.; Vigani, B.; Valentino, C.; Aguzzi, C.; Viseras, C.; Rossi, S.; Sandri, G. Natural and Synthetic Clay Minerals in the Pharmaceutical and Biomedical Fields. Pharmaceutics 2023, 15, 1368. https://doi.org/10.3390/pharmaceutics15051368
Nomicisio C, Ruggeri M, Bianchi E, Vigani B, Valentino C, Aguzzi C, Viseras C, Rossi S, Sandri G. Natural and Synthetic Clay Minerals in the Pharmaceutical and Biomedical Fields. Pharmaceutics. 2023; 15(5):1368. https://doi.org/10.3390/pharmaceutics15051368
Chicago/Turabian StyleNomicisio, Cristian, Marco Ruggeri, Eleonora Bianchi, Barbara Vigani, Caterina Valentino, Carola Aguzzi, Cesar Viseras, Silvia Rossi, and Giuseppina Sandri. 2023. "Natural and Synthetic Clay Minerals in the Pharmaceutical and Biomedical Fields" Pharmaceutics 15, no. 5: 1368. https://doi.org/10.3390/pharmaceutics15051368
APA StyleNomicisio, C., Ruggeri, M., Bianchi, E., Vigani, B., Valentino, C., Aguzzi, C., Viseras, C., Rossi, S., & Sandri, G. (2023). Natural and Synthetic Clay Minerals in the Pharmaceutical and Biomedical Fields. Pharmaceutics, 15(5), 1368. https://doi.org/10.3390/pharmaceutics15051368

